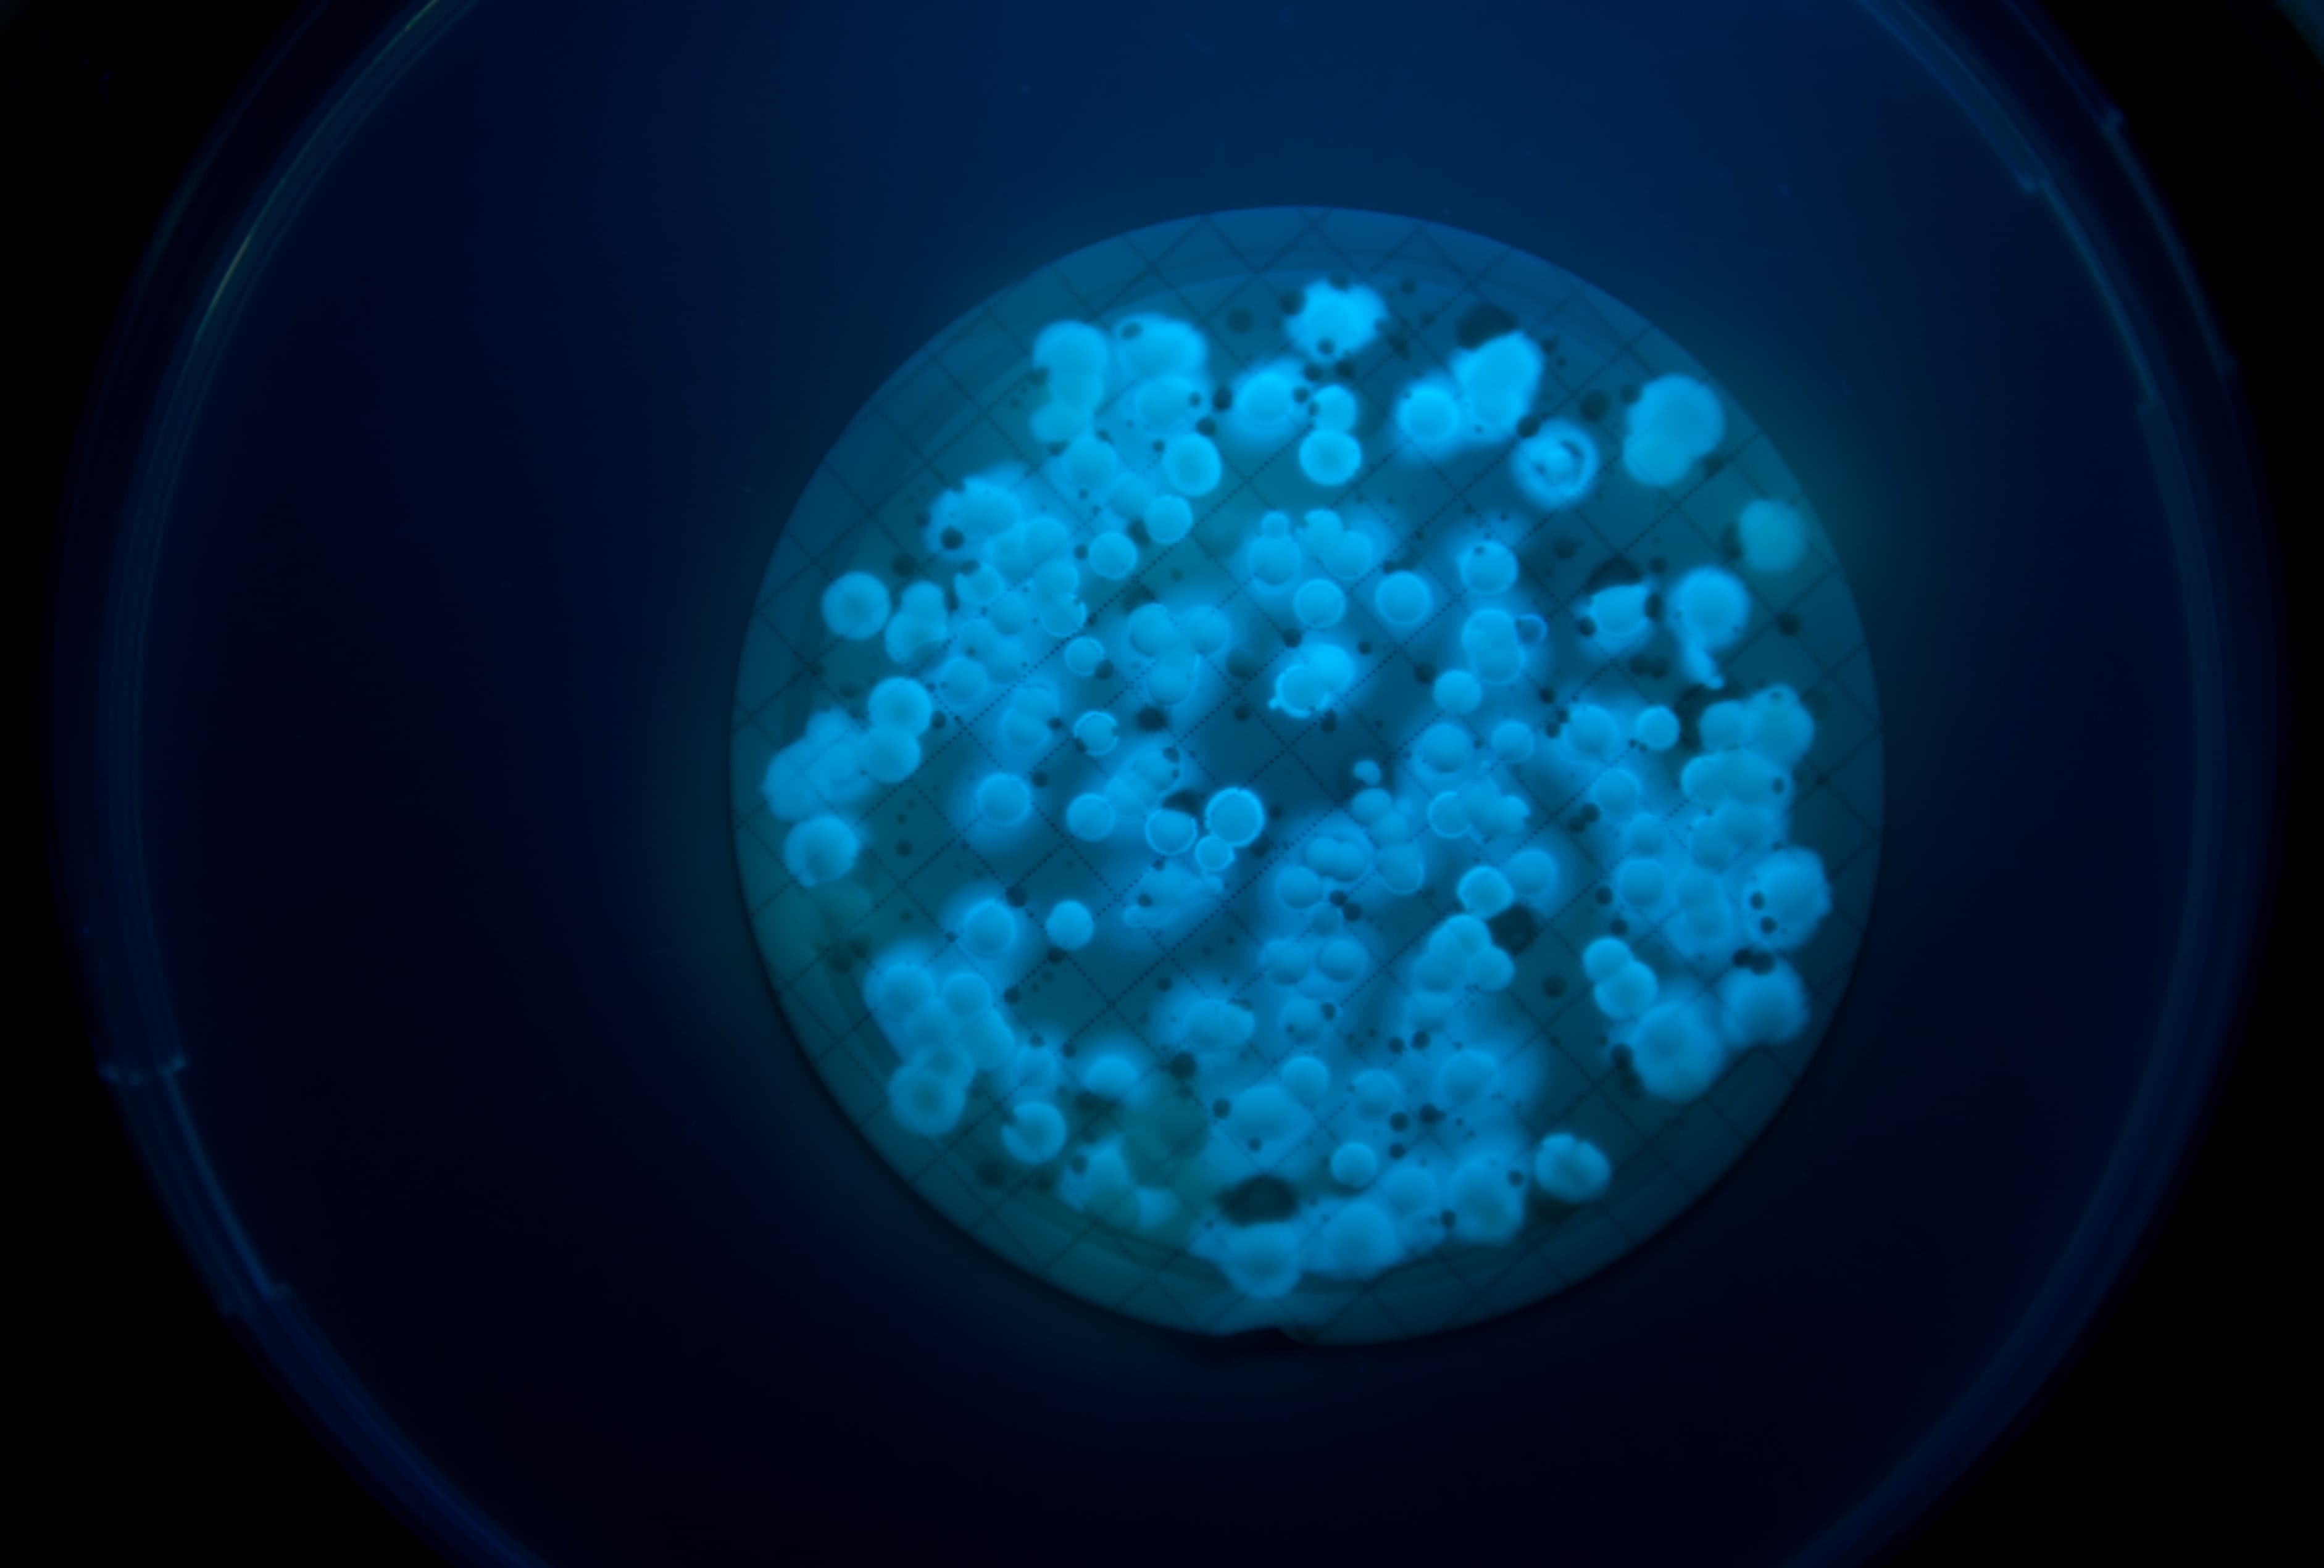
pseudomonas species

ECT Water Microbiology offers comprehensive Pseudomonas species and Pseudomonas aeruginosa testing services.
What Are Pseudomonas Species?
Pseudomonas is a common bacterium that can be found in soil and water. There are over 100 different Pseudomonas species, but Pseudomonas aeruginosa is of significant medical importance due to causing infections in humans while being highly resistant to antibiotics.
Common infections caused by Pseudomonas aeruginosa include pneumonia, UTIs, septicaemia, and GI infections. The people most at risk are those with weak immune systems, such as the elderly, young babies, and anyone with long-term illnesses like cystic fibrosis.
Although other Pseudomonas species rarely affect human health, they can lead to issues such as biofilm formation and corrosion in hot and cold-water systems - which, if left untreated, can be hard to rectify. Generally, stagnant water is what gives Pseudomonas the perfect conditions to grow and multiply.
Our Pseudomonas Species Testing Services
The ECT Water Microbiology laboratory has access to the Biomerieux database, which is constantly being updated with information on new Pseudomonas species. This means you can have peace of mind that any contamination in your water system will be detected by our team.
The testing process is slightly different for Pseudomonas species and Pseudomonas aeruginosa:
- For Pseudomonas species, the water sample is filtered and added to an agar plate with antibiotics that stop the growth of other present bacteria. It is then incubated, and if Pseudomonas growth is found, a biochemical test is carried out for confirmation.
- For Pseudomonas aeruginosa, the process is the same except for the use of a different agar and additional confirmatory tests to check for various factors, including casein hydrolysis and UV fluorescence. The acceptable level is zero Pseudomonas aeruginosa detected.

All samples will be collected by our dedicated drivers and tested within 24 hours in our UKAS*-accredited laboratory.
How to Prevent Pseudomonas
Pseudomonas species testing is particularly important in recreational waters and closed circuit systems. If Pseudomonas is found in your water system, it is a sign that the water quality is compromised. It also suggests the presence of other harmful bacteria, which can cling to and become hidden within Pseudomonas biofilms.
Preventing Pseudomonas begins with how your water system is designed and installed. Design faults such as capped pipes and dead legs can create the ideal stagnant conditions for Pseudomonas species to thrive. If these are installed, they must be looped out and circulated regularly.
You should also consider:
- Carrying out routine water testing
- Maintaining a consistent water temperature of below 20°C
- Checking chlorine levels stay within set parameters
- Regularly treating water with biocide

Pseudomonas Species Testing from CTS Water Microbiology
The best way to identify Pseudomonas species contamination is to have regular testing completed by a water treatment specialist.
At ECT Water Microbiology, our accredited detection method for Pseudomonas species and Pseudomonas aeruginosa ensures reliable, rapid results you can depend on. Plus, our highly experienced and knowledgeable team means you can get expert support with any queries or concerns you may have.
* For a full list of our UKAS-accredited activities, please view our schedule of accreditation.













